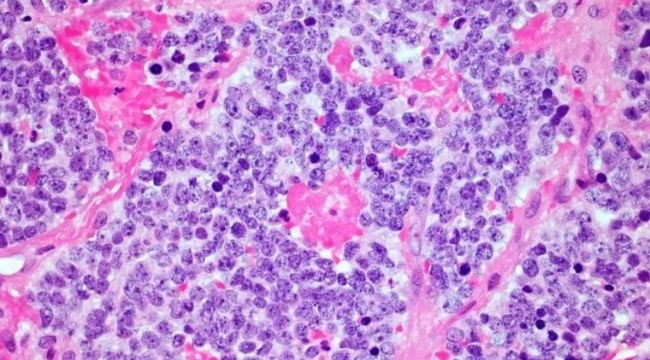
Kanseri tedavisinde çığır açan keşif: CART-T hücreleri görülmemiş başarı sağladı

Kanseri tedavisinde çığır açan keşif: CART-T hücreleri görülmemiş başarı sağladı
Kanser tedavisinde devrim niteliğinde bir gelişme yaşandı! Bilim insanları, genetiği değiştirilmiş CAR T-hücre tedavisinin, ölümcül bir sinir kanseri türü olan nöroblastomaya karşı 18 yıl boyunca etkili olduğunu tespit etti. Bu rekor sürede hastalığın geri dönmemesi, CAR T-hücrelerinin katı tümörlere karşı da işe yarayabileceğini göstererek kanser tedavisinde yeni bir umut ışığı doğurdu.
CAR-T HÜCRE TEDAVİSİ NEDİR?
CAR T-hücre tedavisi, bağışıklık sisteminin T-hücrelerini genetik mühendislik yoluyla değiştirerek kanser hücrelerini hedef almasını sağlayan bir tedavi yöntemidir.Bu yöntemde:
Hastadan alınan T-hücreleri laboratuvar ortamında genetik olarak değiştirilir.
Bu modifiye hücreler, vücuda tekrar enjekte edilerek kanser hücrelerini yok etmek için programlanır.
Günümüzde CAR T-hücre tedavisi, lösemi ve bazı kan kanserleri için başarıyla uygulanmaktadır. Ancak katı (solid) tümörler üzerinde etkili olması çok daha zordur. Nöroblastoma gibi sinir sistemi kanserleri, bağışıklık sisteminden kaçma konusunda oldukça dirençlidir ve bu nedenle tedaviler genellikle başarısız olur.
BİLİM İNSANLARINI ŞAŞIRTAN KANSER VAKASI
Houston’daki Baylor Tıp Fakültesi’nden Cliona Rooney ve ekibi, 2005 yılında nöroblastoma teşhisi konan ve standart tedavilere yanıt vermeyen 4 yaşındaki bir çocuğa CAR T-hücre tedavisi uyguladı.
O zamandan beri hastada hiçbir tümör belirtisi görülmedi!
Bu, CAR T-hücre tedavisiyle elde edilen en uzun süreli tam remisyon olarak kaydedildi.
Araştırmada yer almayan University College London’dan Karin Straathof, bu durumun "CAR T-hücre tedavisiyle sağlanan en uzun süreli iyileşme" olduğunu vurgulayarak, "Bu hasta artık tamamen iyileşmiş kabul edilebilir" dedi.
DAHA FAZLA ARAŞTIRMA GEREKTİRİYOR
Araştırma ekibi, CAR T-hücrelerini daha etkili hale getirmek için yeni stratejiler geliştirmeye çalışıyor. Amaç, hücrelerin daha güçlü olması ve kanseri daha uzun süre baskılamasını sağlamak.Rooney, "Bu tedaviyi daha güçlü hale getirmeliyiz, ancak bunu yaparken toksisiteyi artırmamalıyız" diyerek, tedavinin daha geniş bir hasta grubuna fayda sağlayacak şekilde iyileştirilmesi gerektiğini belirtti.Kaynak:Cumhuriyet.com.tr







YORUMLAR